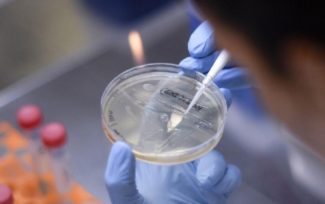

Covid, 2.556 nuovi casi nelle Marche
«Contagi in calo del 43% in 7 giorni»
Diminuisce la pressione sugli ospedali
AGGIORNAMENTO DELLE 15,50 – Continua ad allentarsi la pressione sugli ospedali delle Marche. Nelle ultime 24 ore si sono registrati 13 ricoveri in meno: 3 in meno in terapia intensiva e 10 in meno in area medica. Ad oggi quindi i pazienti Covid nelle Marche sono 348: 47 in terapia intensiva, con una percentuale di occupazione dei posti letto pari al 18,5% e 301 in area medica, con una percentuale di occupazione dei posti letto pari a 29,3%. A questi si aggiungono 42 persone nei pronto soccorso. Sei, invece, le morti registrate. Le vittime: un 83enne di Fabriano, una 93enne di Ripatransone, un 88enne di Montepradone, una 72enne di Montelabbate, un 60enne di Cupramontana e un 81enne albanese che era ricoverato a Torrette. Tutti avevano patologie pregresse.
***
Covid, sono 2.556 i nuovi positivi registrati nelle Marche. E’ quanto emerge dai dati forniti dall’Osservatorio epidemiologico, nelle ultime 24 ore sono stati testati 10.719 tamponi: 6.656 nel percorso nuove diagnosi e 4.063 nel percorso guariti. L’incidenza dei positivi è al 38,4% (ieri 41%), il tasso cumulativo di contagi ogni 100mila abitanti continua a scendere a quota 1.190,95 (ieri 1.289,12). «Continua la regressione della curva epidemica, con questo andamento chiudiamo la settimana con circa 18mila casi/settimana, in riduzione del 43% in comparazione con la settimana prima che ha visto 31mila casi/settimana», fanno sapere dall’osservatorio epidemiologico delle Marche. La provincia che ha fatto registrare più contagi nelle ultime 24 ore è Ancona (736), seguono: Macerata (587), Pesaro-Urbino (446), Ascoli (355), Fermo (325) e 107 da fuori regione. La fascia d’età fra 25-44 anni fa registrare 650 casi, quella 45-59 fa registrare 577 casi. Sono 748 quelli tra i ragazzi da zero a 18 anni, 111 tra 19-24enni, 470 tra over 60. Sono 475 i sintomatici, 811 i contatti domestici, 774 i contatti stretti di casi positivi, 421 i casi in fase di approfondimento epidemiologico, 5 nella casella positivi in ambiente di vita socialità, 49 in setting scolastico/formativo, 6 nei contatti in setting lavorativo, nessuno nei contatti in setting assistenziale, 2 negli screening sanitari e 13 nei casi extra regione. Nelle terapie intensive il 75% dei ricoverati non è vaccinato, il 52% nell’area medica.
Articoli correlati
Covid, 2.935 nuovi casi nelle Marche: l’incidenza dei positivi è al 41% Tasso cumulativo continua a scendere
Quarantena a scuola, le nuove regole: con quanti positivi scatta la dad dalle elementari alle superiori
Covid, 2.519 nuovi casi nelle Marche Lo sfogo di Acquaroli sulla zona arancione: «La gente è stanca e sfiduciata»
Più precisi dei test antigenici rapidi Ecco i cani che fiutano il Covid Dalle Marche il primo studio in Italia
Covid, guarito il sindaco Grillini: «Grazie per la vicinanza manifestata da tantissimi concittadini»
Torna alla home page